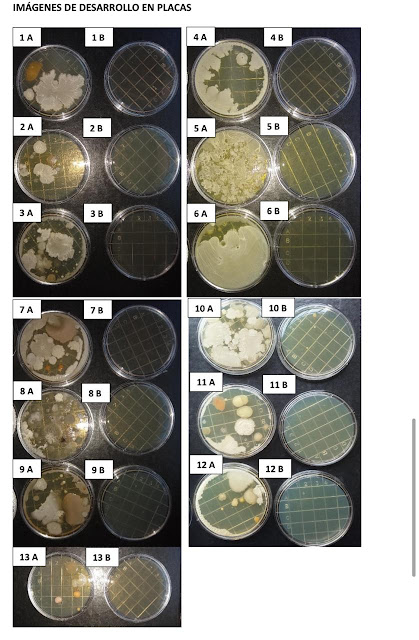

EXITOSA PRUEBA DE LA NUEVA FÓRMULA DE DESINFECCIÓN PARA DISMINUIR EL IMPACTO DEL COVID EN EL TRANSPORTE PÚBLICO
BUENOS AIRES 23 Sept(Prensa Ministerio de Transportes).-Con el objetivo de continuar brindando soluciones innovadoras para el control del COVID-19 en el transporte público, y garantizar así el cuidado del personal esencial que lo utiliza a diario, el Ministerio de Transporte realizó pruebas de un nuevo producto sanitizante para incorporar en procesos de limpieza y desinfección en el transporte.
El producto testeado resultó eficaz en el combate de bacterias, destacándose sobre todo por su efectiva y larga duración en las superficies. Junto a personal del ANLIS Malbrán los testeos se realizaron en formaciones de Trenes Argentinos Operaciones de la línea Roca. Además, se está comenzando en la planificación de prueba de otro producto para uso aerocomercial.
Como desde comienzo del aislamiento social, preventivo y obligatorio, en el marco de la pandemia causada por el COVID-19, el Ministerio de Transporte continúa trabajando para evitar que el transporte público sea un foco de contagio y propagación.
Es en esta línea que se realizaron pruebas de campo de una nueva fórmula para limpiar y desinfectar, en esta primera etapa, unidades de ferrocarriles que circulan diariamente atravesando el Área Metropolitana de Buenos Aires.
Las pruebas, que comenzaron el 10 de septiembre, arrojaron resultados positivos en cuanto a la acción y duración del producto en las distintas superficies de las unidades de la línea Roca.
Tras el éxito de la innovadora fórmula, el objetivo es ampliar su utilización a otras modalidades de transporte mediante un trabajo coordinado con los organismos descentralizados dependientes del Ministerio de Transporte. Para uso aerocomercial, se comenzó a planificar la prueba correspondiente de otro tipo de fórmula de similares características.
Al respecto, el ministro Mario Meoni sostuvo: “Junto a Trenes Argentinos Operaciones y el Instituto Malbrán trabajamos para desarrollar y probar productos de larga duración que nos permitan combatir de manera más efectiva la supervivencia del COVID-19 en superficies, así como otros virus o bacterias en el transporte público.
Asumimos el compromiso, desde que comenzó la pandemia, de proteger tanto a los pasajeros como a los trabajadores en el transporte público, a través de la puesta en marcha de una serie de protocolos de limpieza y desinfección de las unidades, hasta con apps innovadoras para la reserva de uso del tren en las horas pico.
Las pruebas realizadas dieron buenos resultados, lo que nos permitirá incorporar este tipo de producto al protocolo de desinfección en las diferentes modalidades de transporte público de pasajeros”. Durante las pruebas, se aplicó el desinfectante de superficies BIOPLAN 250H al 1% (solución acuosa), utilizando pulverizadores manuales.
Para la desinfección del instrumental de las cabinas de conductores Norte y Sur, se utilizaron paños para no dañar el interior del instrumental. Para el control microbiológico se utilizaron placas RODAC con medio de cultivo TSA con el objetivo de analizar el proceso de desinfección de superficies como asientos, apoya brazos, pisos, ventanas, micrófono etc.
Luego de apoyar el medio de cultivo de la placa sobre la superficie antes de la desinfección, se desinfectó con BIOPLAN 250H al 1% (solución acuosa). Se esperó 15 minutos para que el desinfectante actúe sobre virus y gérmenes presentes. Posteriormente, se apoyó el medio de cultivo de una nueva placa sobre las superficies desinfectadas.
En total, fueron 26 placas fueron incubadas invertidas por 48 h a 35°C, luego de este tiempo se realizó el recuento, que arrojó resultados positivos: hubo un intenso crecimiento bacteriano en las muestras tomadas antes de la desinfección, mientras que luego de la desinfección prácticamente no se observó crecimiento significativo en ninguna de las placas.
A diferencia del hipoclorito, la fórmula testeada es menos agresiva, no irritante en concentración de uso, no es corrosiva y, por lo tanto, no afecta la electrónica de la cabina, no requiere un lavado con desengrasante y no es tóxico para seres humanos, en las dosis recomendadas. Además, a diferencia del hipoclorito no mancha, no se inactiva por la luz solar y no presenta olor penetrante, por lo que su utilización es más amigable.
Asimismo, presenta una estabilidad de 2 años en dilución de uso, lo que permite seguir utilizando el producto preparado sobrante en la siguiente descontaminación. Es altamente eficiente a baja de dosis de uso y tiempos cortos de contacto; tiene un óptimo nivel de penetración y efecto residual.
La fórmula, desarrollada por la empresa Diransa, además de prevenir la propagación del coronavirus, también es efectiva en el combate de otras bacterias, hongos y virus como la escherichia coli, salmonela, hepatitis, influenza, entre otras. Inactiva diferentes virus que causan enfermedades y que están presentes en medios de transportes, establecimientos públicos y privados de salud, industrias, instituciones educativas y oficinas, entre otros.
La acción para disminuir el impacto del coronavirus se realiza junto a personal de Trenes Argentinos Operaciones y profesionales de la ANLIS-Dr. Carlos G. Malbrán, quienes ya elaboraron un reporte en relación a agentes y estrategias para disminuir el impacto del virus en el transporte público.
En coordinación con el Ministerio de Salud, durante la investigación se estudiaron 4 fórmulas, siendo seleccionada una de ellas, por haber sido una de las que mejores resultados demostró y por ser, además, de producción 100% nacional.

No hay comentarios.:
Publicar un comentario